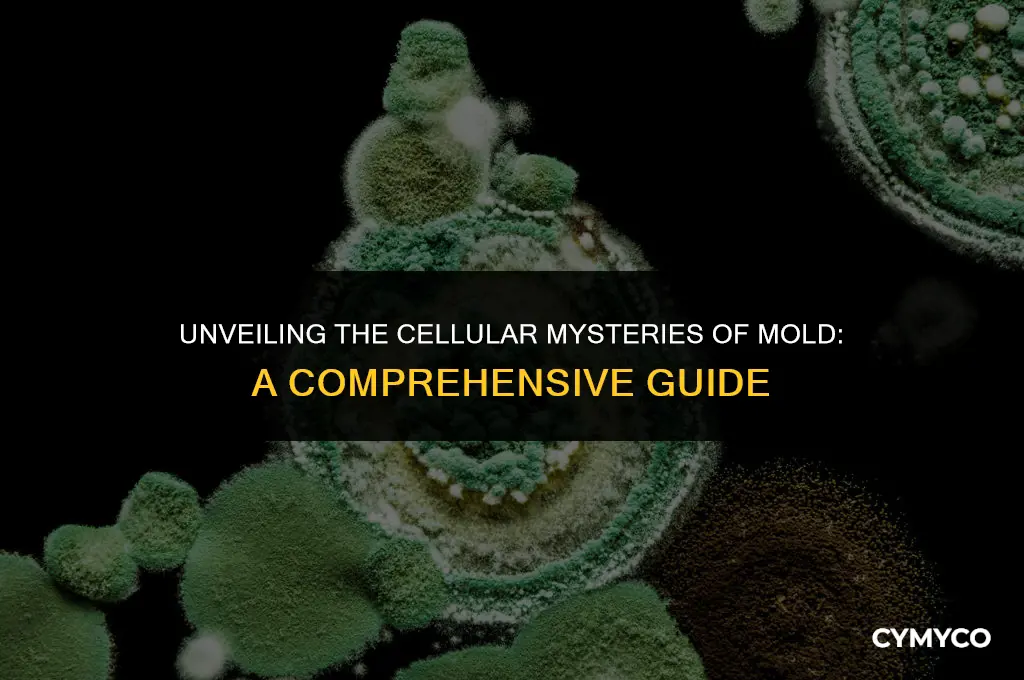
is mold unicellular or multicellular

Mold is a type of fungus that can be found in various environments, often thriving in damp and humid conditions. It plays a crucial role in decomposing organic matter, recycling nutrients back into the ecosystem. Mold can appear in different colors, shapes, and sizes, and is commonly associated with spoilage and decay. Understanding whether mold is unicellular or multicellular is essential in grasping its biology and ecological significance. Unicellular organisms consist of a single cell, while multicellular organisms are made up of multiple cells that work together to perform various functions. In the case of mold, it is classified as a multicellular organism, as it is composed of numerous cells that collaborate to form the visible mold structure we often encounter.
| Characteristics | Values |
|---|---|
| Cell Structure | Mold is a multicellular organism, composed of numerous cells that differentiate and specialize to form various structures such as hyphae, mycelium, and spores. |
| Cell Type | Mold cells are eukaryotic, containing a true nucleus and membrane-bound organelles. |
| Reproduction | Mold reproduces both sexually and asexually. Asexual reproduction occurs through the formation of spores, while sexual reproduction involves the fusion of haploid nuclei. |
| Growth Form | Mold typically grows as a network of branching filaments called hyphae, which collectively form a mass known as mycelium. |
| Nutrition | Mold is heterotrophic, obtaining nutrients by decomposing organic matter. It secretes enzymes to break down complex organic compounds into simpler substances that can be absorbed. |
| Habitat | Mold can be found in a wide range of environments, including soil, decaying organic matter, and indoor surfaces with adequate moisture and organic material. |
| Temperature Range | Most molds thrive in temperatures between 70°F and 90°F (21°C and 32°C), though some species can grow in colder or hotter conditions. |
| Moisture Requirement | Mold requires moisture to grow, typically needing a relative humidity of 60% or higher. |
| Light Requirement | While some molds prefer dark environments, others can grow in the presence of light. The specific light requirements vary by species. |
| Air Requirement | Mold needs oxygen to grow, as it is an aerobic organism. |
| Growth Rate | The growth rate of mold varies depending on environmental conditions and species, but it can spread rapidly under favorable conditions. |
| Health Impact | Some molds produce mycotoxins that can be harmful to humans and animals if ingested, inhaled, or contacted through skin. |
| Allergenic Potential | Mold spores can be allergens, causing respiratory issues and other allergic reactions in sensitive individuals. |
| Ecological Role | Mold plays a crucial role in ecosystems by decomposing organic matter and recycling nutrients back into the environment. |
| Industrial Uses | Mold is used in various industrial processes, including the production of antibiotics, enzymes, and fermented foods such as cheese and bread. |
Explore related products
$22.99 $23.99
What You'll Learn
- Mold Classification: Understanding the biological categorization of mold as a fungus
- Cell Structure: Exploring whether mold consists of single cells or multiple cells
- Growth Patterns: How mold propagates and forms visible colonies
- Reproduction: The methods by which mold reproduces, including spore formation
- Ecological Role: Mold's function in ecosystems, such as decomposing organic matter

Mold Classification: Understanding the biological categorization of mold as a fungus
Mold, a common household problem, belongs to the kingdom Fungi, which is a distinct group of eukaryotic organisms. Unlike plants and animals, fungi lack chloroplasts and do not perform photosynthesis. Instead, they obtain nutrients by decomposing organic matter. Molds are a type of fungus known as filamentous fungi, characterized by their branching, thread-like structures called hyphae. These hyphae form a network called a mycelium, which is the vegetative part of the fungus.
The classification of mold as a fungus is based on several key characteristics. Firstly, molds have a cell wall composed of chitin, a polysaccharide not found in plant or animal cells. Secondly, their hyphae are typically septate, meaning they have cross-walls that divide the hyphae into compartments. Thirdly, molds reproduce via spores, which are produced in specialized structures such as conidiophores. These spores are dispersed into the environment and can germinate into new mold colonies under suitable conditions.
Understanding the biological categorization of mold is crucial for effective mold remediation and prevention. For instance, knowing that molds thrive in damp, warm environments can help in identifying and addressing the root causes of mold growth in homes. Additionally, recognizing that molds can produce mycotoxins, which can be harmful to human health, underscores the importance of proper mold handling and removal.
In conclusion, mold classification as a fungus provides valuable insights into its biology, ecology, and potential impacts on human health and the environment. This knowledge is essential for developing effective strategies for mold management and prevention.
Identifying the Phylum of the Fungus in the Image: A Guide
You may want to see also
Explore related products
$24.95

Cell Structure: Exploring whether mold consists of single cells or multiple cells
Mold is a type of fungus that can be found in various environments, both indoors and outdoors. One of the key characteristics that define mold is its cellular structure. Mold can be classified as either unicellular or multicellular, depending on the species and the stage of its life cycle. Unicellular molds consist of a single cell, while multicellular molds are made up of multiple cells that are connected to each other.
The cellular structure of mold plays a crucial role in its ability to grow and reproduce. Unicellular molds typically reproduce through the process of binary fission, where a single cell divides into two identical daughter cells. On the other hand, multicellular molds reproduce through the formation of spores, which are produced by specialized cells called sporocytes. These spores can then germinate and develop into new mold colonies.
One of the most common types of mold is Penicillium, which is a multicellular fungus. Penicillium mold is often found in indoor environments and can cause allergic reactions in some people. Another example of a multicellular mold is Aspergillus, which is a genus of fungi that includes several species that can cause serious health problems in humans.
In contrast, some molds are unicellular, such as the genus Saccharomyces, which includes several species of yeasts. Yeasts are commonly used in baking and brewing, and they play an important role in the fermentation process.
Understanding the cellular structure of mold is essential for developing effective strategies for preventing and controlling mold growth. For example, some mold remediation techniques are more effective against unicellular molds, while others are more effective against multicellular molds. Additionally, the cellular structure of mold can impact its ability to resist environmental stressors, such as temperature and humidity changes.
In conclusion, mold can be classified as either unicellular or multicellular, depending on the species and the stage of its life cycle. The cellular structure of mold plays a crucial role in its ability to grow, reproduce, and resist environmental stressors. Understanding the cellular structure of mold is essential for developing effective strategies for preventing and controlling mold growth.
Can Soap Effectively Eliminate Fungi? Exploring Its Antimicrobial Properties
You may want to see also
Explore related products

Growth Patterns: How mold propagates and forms visible colonies
Mold's growth patterns are a fascinating aspect of its biology, showcasing both its unicellular origins and its ability to form complex multicellular structures. Mold propagates through the release of spores, which are microscopic, unicellular entities capable of surviving in various environmental conditions. When these spores land on a suitable substrate, such as damp wood or fabric, they germinate and begin to grow.
The initial growth phase is characterized by the formation of hyphae, which are long, branching filaments. These hyphae are multicellular, consisting of a series of connected cells that work together to absorb nutrients from the substrate. As the mold continues to grow, the hyphae form a network known as a mycelium, which can spread extensively throughout the substrate.
One of the most distinctive features of mold growth is the formation of visible colonies. These colonies are typically composed of a dense mass of hyphae and can vary in color, texture, and size depending on the species of mold and the environmental conditions. The colonies may appear as fuzzy patches, slimy films, or even as intricate, branching structures.
The process by which mold forms these visible colonies is complex and involves several stages. Initially, the spores germinate and form hyphae, which then spread out and explore the substrate. As the hyphae grow, they begin to produce secondary metabolites, which can give the mold its characteristic color and odor. Finally, the hyphae form a dense network, which eventually becomes visible to the naked eye as a colony.
Understanding mold's growth patterns is crucial for preventing and controlling mold infestations. By recognizing the early stages of mold growth, such as the formation of hyphae and the initial appearance of colonies, it is possible to take steps to mitigate the spread of mold and prevent it from causing damage to buildings, food, and other materials.
Unveiling the Mysteries: A Comprehensive Guide to Diagnosing Fungi
You may want to see also
Explore related products

Reproduction: The methods by which mold reproduces, including spore formation
Mold reproduces through both sexual and asexual means, with spore formation being a critical aspect of its life cycle. Spores are microscopic structures that are highly resistant to environmental stresses, allowing them to survive in harsh conditions and disperse over long distances. When conditions are favorable, these spores germinate and grow into new mold colonies.
One of the primary methods of mold reproduction is through the production of asexual spores. This process, known as sporulation, involves the formation of specialized structures called sporangia, which contain the spores. The sporangia can be found on the surface of the mold or within its hyphae, and they release the spores into the environment when mature.
In addition to asexual reproduction, mold can also reproduce sexually. This process involves the fusion of two compatible hyphae, followed by the formation of a zygote. The zygote then undergoes meiosis, resulting in the production of sexual spores. Sexual reproduction is less common than asexual reproduction in mold, but it can occur under certain conditions.
The ability of mold to reproduce through both sexual and asexual means allows it to adapt to a wide range of environments and conditions. This adaptability is one of the reasons why mold is such a successful and widespread organism. Understanding the reproductive processes of mold is important for controlling its growth and preventing its spread in indoor environments.
Exploring the Fascinating World of Fungi Kingdom
You may want to see also
Explore related products

Ecological Role: Mold's function in ecosystems, such as decomposing organic matter
Molds play a crucial ecological role in ecosystems by decomposing organic matter. This process is essential for nutrient cycling and maintaining the balance of natural environments. As decomposers, molds break down dead plant and animal material, converting it into simpler substances that can be absorbed by other organisms. This function is particularly important in forest ecosystems, where molds help to recycle nutrients from fallen leaves and dead wood, making them available to plants and other organisms.
The decomposition process carried out by molds involves the secretion of enzymes that break down complex organic compounds into smaller molecules. These enzymes are highly specialized and can target specific types of organic matter, such as cellulose, lignin, and proteins. By breaking down these compounds, molds release essential nutrients like nitrogen, phosphorus, and potassium back into the soil, where they can be taken up by plants and other organisms.
In addition to their role in nutrient cycling, molds also contribute to the formation of soil structure. As they grow and decompose organic matter, molds produce a network of fine filaments called hyphae. These hyphae help to bind soil particles together, improving soil aggregation and water retention. This, in turn, creates a more favorable environment for plant growth and supports the overall health of the ecosystem.
Molds' ecological role is not limited to terrestrial ecosystems. They are also found in aquatic environments, where they play a similar role in decomposing organic matter and recycling nutrients. In some cases, molds can even help to clean up polluted environments by breaking down harmful chemicals and toxins.
In conclusion, molds are essential components of ecosystems, serving as decomposers that break down organic matter and recycle nutrients. Their ecological role is vital for maintaining the balance of natural environments and supporting the growth and survival of other organisms.
Exploring the Nutritional Nature of Fungi: Autotroph or Heterotroph?
You may want to see also
Frequently asked questions
Mold is multicellular.
Mold is classified as a fungus.
Mold reproduces through the production of spores.
Some common types of mold include Aspergillus, Penicillium, and Fusarium.











































